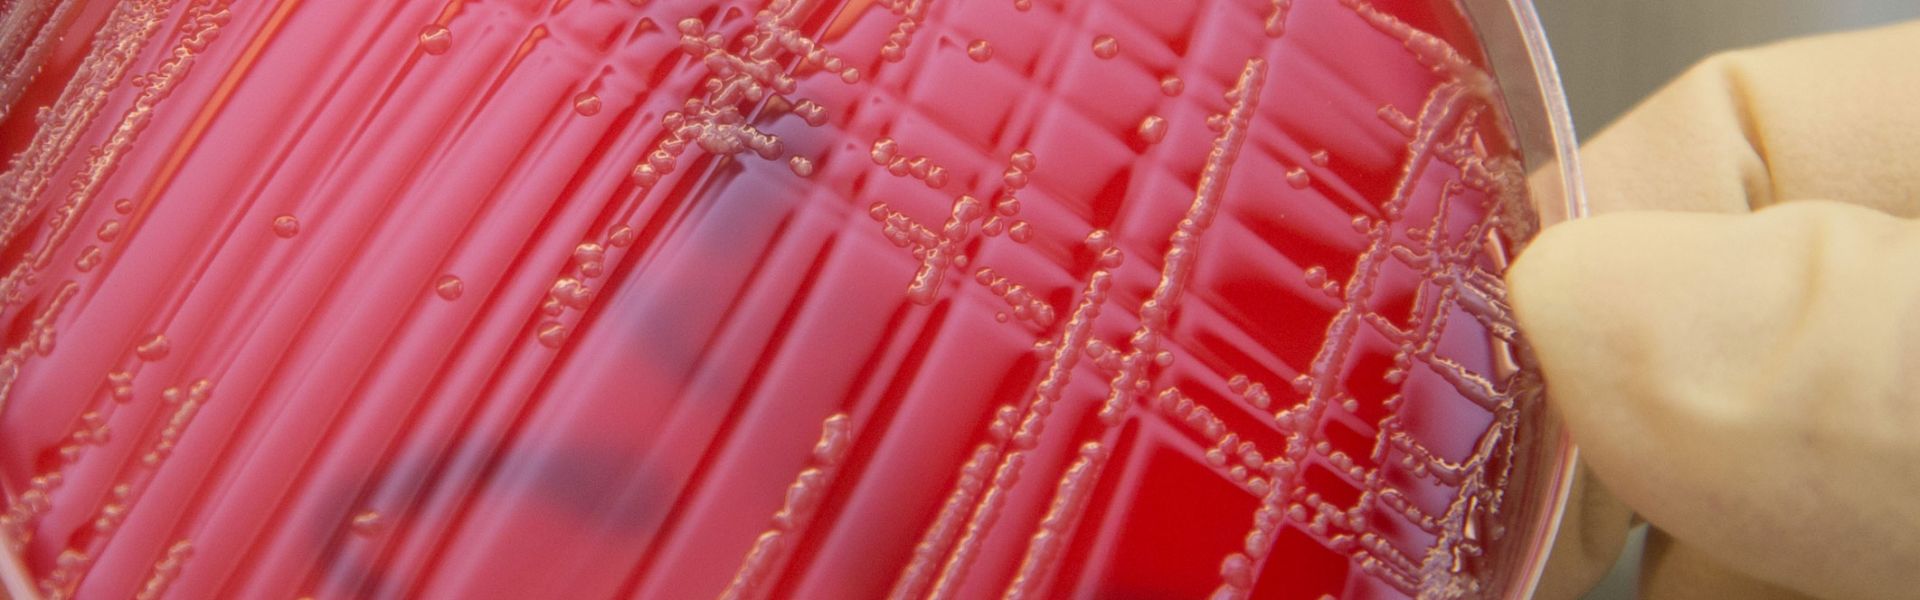

Campylobactériose
Les oiseaux, sauvages comme domestiques, représentent les principaux réservoirs de C. jejuni et de C. coli. Cependant d’autres réservoirs primaires ont été décrits : les bovins, les porcins (essentiellement C. coli) et les petits ruminants, mais aussi les animaux de compagnie (chats et chiens).
Même si certaines espèces de Campylobacter sont pathogènes pour les animaux, et impliquées dans des problèmes d’infertilité ou d’avortements, C. jejuni et C. coli sont considérés comme peu ou pas pathogènes pour les animaux.
La voie principale de transmission de Campylobacter à l’Homme est alimentaire, via des produits contaminés, y compris les eaux de boisson dont le traitement est défaillant. La transmission directe, par un autre individu, un animal (notamment de compagnie) infecté ou une carcasse contaminée, se produirait plus fréquemment pour certaines populations exposées (éleveurs, vétérinaires, ouvriers d’abattoirs, égoutiers, etc.).
La maladie
La maladie humaine la plus fréquemment observée est une entérite aiguë (symptômes : diarrhée, douleurs abdominales, selles sanguinolentes, fièvre, maux de tête, vomissements) causée par une infection intestinale.
L’infection peut se compliquer (dans moins d’un cas sur 100) par une bactériémie, des localisations secondaires et un syndrome post-infectieux (moins d’un cas sur 1000). L’individu infecté reste toutefois contagieux pour une durée moyenne de 38 jours (maximum 70 jours).
Exceptionnellement, C. jejuni peut être à l’origine d’un syndrome post-infectieux de type arthritique, d’inflammation hépatique ou rénale, et surtout du syndrome de Guillain-Barré qui se manifeste par une paralysie temporaire du système nerveux périphérique. Ce syndrome est réputé comme très sévère, avec une mortalité et des séquelles neurologiques majeures.
Tout individu est susceptible de développer une campylobactériose. Cependant, la propension à en développer les formes les plus sévères est accrue chez les personnes :
- âgées ;
- alcooliques ;
- ayant un antécédent de chirurgie digestive ;
- sous dialyse péritonéale (insuffisance rénale) ;
- dont le système immunitaire est affaibli (sous immunodépresseurs, ou atteintes d’une pathologie auto-immune comme l’infection par le VIH).
Situation de l’infection et aliments fréquemment contaminés
Depuis le début des années 2000, le décompte annuel (incidence) des cas de campylobactérioses humaines est régulièrement supérieur à 40 cas recensés pour 100 000 habitants (majoritairement en été) dans l’Union européenne. En France, le Centre national de référence (CNR) fait état de 6,2 cas recensés pour 100 000 habitants en 2009, du fait d’une importante sous déclaration médicale.
La plupart des cas décrits sont isolés les uns des autres (sporadiques).
Les toxi-infections alimentaires collectives (TIAC) liées à Campylobacter sont souvent corrélées à la consommation d’eau, de lait cru ou de viandes de volailles contaminés.
Les transferts de contamination par la planche à découper ou les couteaux qui ont servi à la manipulation de volailles crues, la consommation de viandes insuffisamment cuites (volailles, bovines, porcines), apparaissent comme les principaux facteurs de risques.
Du fait, à la fois, de l’existence de réservoirs animaux et des possibilités nombreuses de transferts de contamination, beaucoup de catégories d’aliments (y compris l’eau) peuvent être contaminées, même si les viandes et produits carnés sont à considérer en premier.
Les moyens de maîtrise de la contamination
D’une manière générale, la congélation arrête la croissance de ces bactéries et détruit vraisemblablement une faible partie de la population bactérienne, surtout en milieu liquide. En revanche, ces bactéries survivent bien aux températures de réfrigération (0 à 10 °C).
Les bactéries sont également très sensibles à la chaleur : on peut considérer que des traitements thermiques supérieurs à 65 °C permettent leur destruction quel que soit le support (liquide ou solide).
Notons, enfin, que ces bactéries ne présentent pas de caractères particuliers de résistance au sel ou aux acides.
Les risques de campylobactériose peuvent être largement limités par l’adoption de bonnes pratiques d’hygiène à la maison. Il est ainsi essentiel de :
- se laver les mains après la manipulation de viandes crues ;
- utiliser une planche à découper pour les viandes et poissons crus, et une autre pour les autres aliments ;
- nettoyer rigoureusement la planche, le plat et les ustensiles ayant servi à l’assaisonnement et à la préparation de la viande crue avant réutilisation ;
- s’assurer d’une cuisson suffisante (> 65 °C à cœur) des viandes de volailles et de boucherie, notamment la cuisson au barbecue : la jointure cuisse/haut de cuisse du poulet ne doit pas être rosée ou présenter de traces de sang ;
- manipuler ces viandes dans de bonnes conditions d’hygiène lors de la préparation et de la consommation de ce type de denrées ;
- ne pas consommer de viande de volaille crue (de type « carpaccio »).
Rôle de l’Anses
Le laboratoire de sécurité sanitaire de Ploufragan-Plouzané (Anses) est reconnu Laboratoire National de Référence, ou LNR, pour Campylobacter.
Le Laboratoire de référence de l'Union européenne (LR-UE) pour Campylobacter (réseau composé, entre autres, des LNR européens) est hébergé par le National Veterinary Institute, SVA, à Uppsala (Suède).
Jusqu’à présent, la recherche de Campylobacter dans les produits alimentaires finis ne faisait pas l’objet d’une réglementation spécifique. Toutefois, le règlement (CE) n° 2073/2005 amendé par le règlement (UE) 2017/1495, et entré en vigueur en Janvier 2018, a introduit un critère d’hygiène des procédés pour Campylobacter sur les carcasses de poulet de chair à l’abattoir.
Par ailleurs, le LNR a publié plusieurs articles scientifiques et rapports sur les risques liés à Campylobacter dans les élevages et dans la chaîne alimentaire du poulet de chair, sur l’attribution des sources de campylobactériose et les stratégies de maîtrise.

Aller plus loin
Zoonoses : comprendre les maladies transmissibles de l’animal à l’homme
Les zoonoses, ces maladies transmissibles de l’animal à l’humain, sont au cœur des enjeux de santé publique et de santé animale. Rage, grippe aviaire, tuberculose bovine, ou encore coronavirus : de nombreux agents pathogènes - bactéries, virus ou parasites - circulent entre les animaux domestiques, la faune sauvage et les êtres humains. Chaque année, plusieurs nouvelles maladies humaines émergent à partir du monde animal, soulignant l’importance d’une surveillance renforcée. Ce dossier vous propose un tour d’horizon des principales zoonoses surveillées en France, des travaux de recherche menés pour mieux comprendre leur transmission, et des actions de l’Anses pour protéger à la fois la santé des animaux, des éleveurs, des vétérinaires et du grand public.


